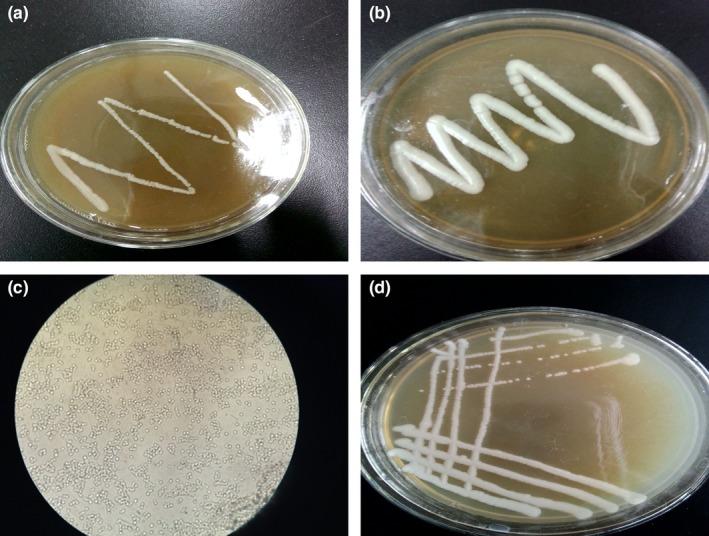

筛选、鉴定及低能离子诱变选育高产 3-羟基丙酸酵母菌株。
Screening, identification, and low-energy ion modified breeding of a yeast strain producing high level of 3-hydroxypropionic acid.
机构信息
Jiangsu Key Construction Laboratory of Food Resource Development and Quality Safe, Xuzhou University of Technology, Xuzhou, P. R. China.
出版信息
Microbiologyopen. 2020 Jan;9(1):e00956. doi: 10.1002/mbo3.956. Epub 2019 Oct 20.
3-Hydroxypropionic acid (3HP) is an important platform chemical with a wide range of applications. The biological preparation of this compound is safe and low cost. In this study, orchard soil and human waste were used as raw materials to screen microbial strains that could produce 3HP in selective medium containing varying amounts of propionic acid. A yeast strain that can use propionic acid as substrate and produce 48.96 g/L 3HP was screened. Morphological observation, physiological and biochemical identification, and 26s rDNA sequencing identified the IS451 strain as Debaryomyces hansenii. The low-energy ion N , with the energy of 10 keV and a dose of 70 × 2.6 × 10 ions/cm , was implanted into the IS451 strain. The mutant strain WT39, whose 3HP titer reached 62.42 g/L, was obtained. The strain exhibited genetic stability and tolerance to high concentrations of propionic acid and was considered to have broad application prospects.
3-羟基丙酸(3HP)是一种重要的平台化学品,具有广泛的应用。该化合物的生物制备安全且成本低。本研究以果园土和人粪为原料,在含有不同浓度丙酸的选择性培养基中筛选能够产生 3HP 的微生物菌株。筛选出一株能够利用丙酸作为底物并产生 48.96 g/L 3HP 的酵母菌株。通过形态观察、生理生化鉴定和 26s rDNA 测序,将 IS451 菌株鉴定为汉逊德巴利酵母。采用能量为 10 keV、剂量为 70×2.6×10 离子/cm 的低能离子 N 对 IS451 菌株进行注入,得到 3HP 产量达到 62.42 g/L 的突变株 WT39。该菌株表现出遗传稳定性和对高浓度丙酸的耐受性,具有广阔的应用前景。